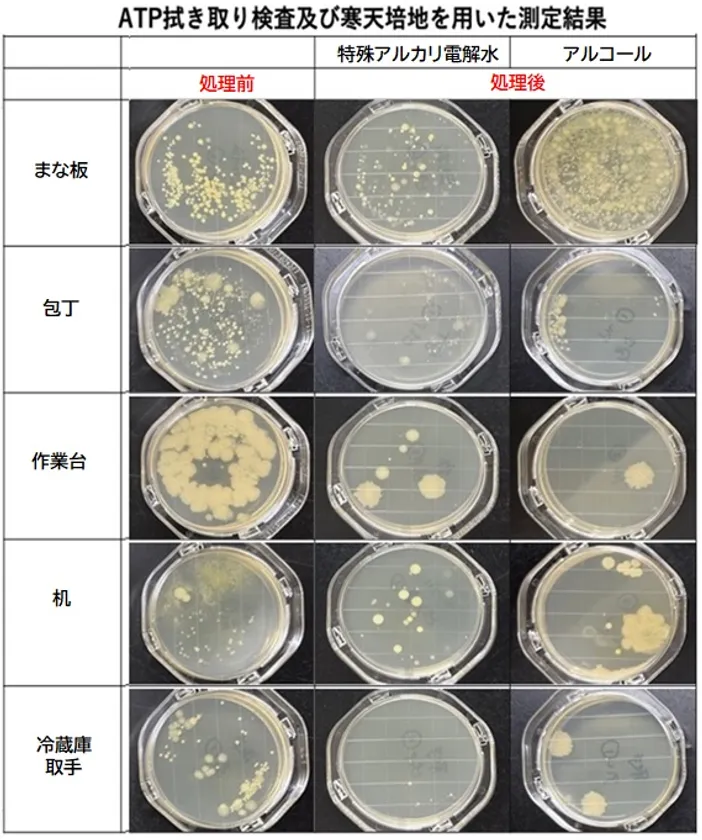

「ZENON 特殊アルカリ電解水/SDGs レポート(4)」 鹿児島大学・株式会社キャンパスクリエイトとの共同研究 ~研究テーマ:殺菌と洗浄における効果効能について~
株式会社ゼノン(本社:東京都中野区/代表取締役社長:阿部 昭典)は、独自技術で生成したZENON特殊アルカリ電解水が、【医学的に正しく、社会貢献が大きく期待される製品】として、「奈良県立医科大学・MBTコンソーシアム」から、<MBTロゴマーク>の使用許諾を受けスタートした『SDGs レポート』の第四弾を、「SDGs レポート(4)」として2024年4月8日に公式サイトで公開いたしました。
第四弾は、鹿児島大学・株式会社キャンパスクリエイトとの共同研究として、以下の3つ研究テーマを設定したもので、2022年4月より行ってきた殺菌・洗浄に関する3つの試験報告書を使用いたしました。
<詳細: https://znn.co.jp/news/ >
【(1) 殺菌編】大腸菌浮遊細胞増殖およびバイオフィルム生成抑止効果の検証
【(2) 洗浄編】焼酎などの醸造工程で発酵タンク壁面に付着する「芋やに」とも呼ばれる強固に付着し、洗浄が困難な油脂の洗浄効果の検証
【(3) 比較編】飲食店(鹿児島市)の厨房を使用してのアルコール・化学洗剤との抗菌・洗浄効果の比較検証
※研究者:鹿児島大学大学院 農林水産学研究科 食品創成科学専攻
小方 麻記子、呉 トウキョウ、紙谷 喜則(准教授)
※コーディネーター:株式会社キャンパスクリエイト
※報告書内では、ZENON特殊アルカリ電解水を「SAW=超アルカリ性電解水」、他社製の強アルカリ性電解水を「AlEW=強アルカリ性電解水」と表記し比較しています。

鹿児島大学

鹿児島大学

芋やにの洗浄効果の検証

飲食店での洗浄殺菌効果の比較
ATP拭き取り検査の結果
【研究報告書/簡易版】
※全文は、当社ホームページ内で公開しています
【緒言】
《前略》本研究は、SAWを独自装置で生成し製造販売している株式会社ゼノンと、鹿児島大学・株式会社キャンパスクリエイトの共同研究として、webなどで標榜されている超アルカリ性電解水の殺菌効果と洗浄効果や効能について検討する。
【超アルカリ性電解水の性状】
SAW(=ZENON 特殊アルカリ電解水)は、《中略》この強塩基性により、コロナウイルスなどの不活化や大腸菌などの生育を阻害することで殺菌効果を有する可能性および、油脂などの洗浄効果を有することが株式会社ゼノンの共同委託実験(奈良県立医科大学)により確認されている。SAWは洗浄効果と殺菌効果を両立した新たな洗浄剤として期待されている。《後略》
【(1) 殺菌編】
大腸菌浮遊細胞増殖およびバイオフィルム生成抑止効果の検証
【要約/結果】
食品接触面に付着したバイオフィルムは、相互汚染を引き起こし、食品の安全性に対する重大な脅威を伴う食品媒介性疾患の発生を引き起こす可能性がある。《中略》SAWのこれらの効果は、飲食店などにおける新たな洗浄剤として衛生的な環境を保つために使用することで薬剤の代替品として有望であると考えられる。
(1)超アルカリ性電解水(SAW)の抗菌活性
《前略》SAW処理後、生き残った大腸菌数は、減少傾向を示したことからSAWは大腸菌に対して抗菌効果を持つことを確認した。《後略》
(2)食品接触面上の大腸菌浮遊細胞に対する抗菌効果
本実験では、これら2つの食品接触面に対する大腸菌浮遊細胞に対する各試料水の抗菌効果の結果を図2に示す。《後略》
(3)食品接触面上の大腸菌バイオフィルム観察
《前略》AlEW(他社製の強アルカリ性電解水)は、大腸菌バイオフィルム量を減少させるが、完全に除去することはできないことが示されたのに対してSAWは8-12時間経過後には検出限界を下回ったことから、AlEWより高い除菌効果を有していることが示された。《後略》
【(2) 洗浄編】
汚染サンプルに付着させた「さつま芋由来油脂“芋やに”」の洗浄効果の検証
【結果】
超アルカリ性電解水(SAW)の“芋やに”洗浄効果
《前略》塩基性が高いことで食品接触面からの芋やに汚染物質の除去をより助長したことが確認できた。また、焼酎醸造所で使用されている市販の洗剤と同等の洗浄効果を確認した。ステンレス表面で確認できた事象は、ガラス表面でも同様に観察できたことから食品業界で有望な見通しがあります。《後略》
【(3) 洗浄編】
飲食店(郷土料理店)における超アルカリ性電解水と、アルコール・化学洗剤の洗浄・殺菌効果の比較検証
【目的/概要】
《前略》 生活排水による環境問題解決のために、化学薬品の代替として水と炭酸カリウムで生成された超アルカリ性電解水を洗浄に用いることが期待されている。《中略》 洗浄および殺菌効果について、郷土料理系飲食店で実際に使用されている「アルコール」や「化学薬品洗剤」との殺菌・洗浄効果について検証した。
【結果/考察】
《前略》超アルカリ性電解水は対象物の素材によっては78%アルコールと同等の抗菌効果を持つと考えられる。今後の展望として、超アルカリ性電解水の洗浄効果の検証を行い、タンパク質汚れや脂質汚れなど、汚れの種類によって見られる洗浄・殺菌効果の違いを追求する。《後略》
図1 一般生菌数の測定結果

一般生菌数の測定結果(1)
図2 まな板の一般性菌数の測定結果

一般生菌数の測定結果(2)
【関連ニュースリリース】 https://znn.co.jp/news/
「SDGs レポート(3)/介護・福祉施設における活用事例の紹介」(2023年4月)
「SDGs レポート(2)/医師も推薦・歯科クリニックでの活用事例の紹介」(2022年3月)
「SDGs レポート(1)/フードデリバリー業界のコロナウイルス対策・衛生管理」(2021年9月)
「ZENON 特殊アルカリ電解水<除菌洗浄水>」の3大特徴(当社製品名:ピュアステラ)

ZENON特殊アルカリ電解水/3大特徴

ZENON特殊アルカリ電解水/ピュアステラ

SDGs
■会社概要
商号 : 株式会社ゼノン
代表者 : 代表取締役社長 阿部 昭典
本社 : 〒165-0032 東京都中野区鷺宮5-6-23
営業部 : 〒176-0012 東京都練馬区豊玉北4-26-6 1F
設立 : 1989年11月(平成元年11月27日)
事業内容: 事業内容: 特殊アルカリ電解水の製造販売
スポーツ施設の経営、運営及び管理 他
資本金 : 1,000万円
URL : https://znn.co.jp/






















